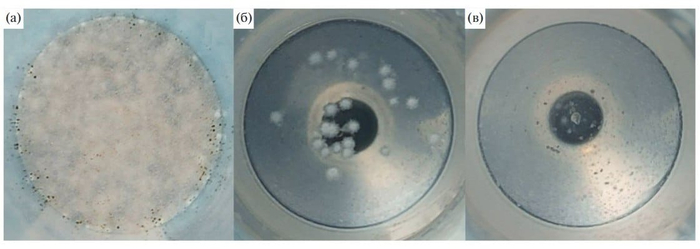
���� Aspergillus niger F-4815D ����� ���� ����� ����� ������: � � �� ����� � ��������� ��� ���������������, � � �� ����� � 0,01% ��������������� � ���������, � � �� ����� � 0,01% ��������������� ��� �������� / � ���������� � ��������������

Вид: Scopophacus oculofugas. Объект БП-7. Отчёт Лаборатории биоаномалий. Научная справка №447-БП/ВС. [РАСЕКРЕЧЕНО] СМАЯ
СЛУЖБА МОНИТОРИНГА АНОМАЛЬНЫХ ЯВЛЕНИЙ
ЛАБОРАТОРИЯ БИОАНОМАЛИЙ (сектор 7-Г)
Документ: НС-447-БП/ВС | Уровень доступа: ДЛЯ СЛУЖЕБНОГО ПОЛЬЗОВАНИЯ
Дата публикации выдержки: 03.01.2026
ТАКСОНОМИЯ И ОБЩАЯ ХАРАКТЕРИСТИКА
Ц. Zoa
П/ц. Parazoa
Т. Aberratio
П/т. Vitreozoa
Кл. Diphanoptera
В. Scopophacus oculofugas (от лат. scopos — цель, наблюдатель; phakos — линза; oculus — глаз; fugare — обращать в бегство)
Первичное обнаружение: 14.08.1998, сектор 4-В, образец из стеклопакета жилого дома по ул. Ленина, 17 (после инцидента №998-ГК с потерей ориентации жильца).
Ответственный исследователь: ст. н. с. Лаб. биоаномалий, к.б.н. В.И. Аникин (репрессирован за нарушение протокола 12-Г в 2003 г.).
Организм является одноклеточным эукариотом, существующим исключительно в форме колониального синцития – витреобиозма. Нервная система отсутствует, её функции замещены распределённой фото-механохимической сигнальной системой, интегрированной в витреолемму и фотонный синовий.
МОРФОЛОГИЯ И УЛЬТРАСТРУКТУРА (на стадии трофозоита)
- Размер клетки: 80-120 нм.
- Клеточная оболочка – витреолемма (Vitreolemma): Двойной слой аморфных силикатных пластин в матрице гликопротеинов витрозинов (n=1.51). Обеспечивает оптическую маскировку и, при синхронной перестройке актомиозиновым кортексом, изменение коэффициента преломления (Δn до 0.02) с образованием макроскопических интерференционных узоров.
- Ядро содержит единственную аномальную кольцевую хромосому, что противоречит канонам эукариотической организации. Данный признак, наряду с наличием ядра, позволяет отнести организм к гипотетическому надцарству Parazoa Aberratio – «исключительных существ с химерной клеточной архитектурой». Предполагается, что кольцевая структура хромосомы является адаптацией для более эффективной репликации res-RNA в условиях стеклянной матрицы». Присутствуют Nucleolus aberrans, продуцирующий «резонансные РНК» (res-RNA) для феномена «Стеклального резонанса» – квантово-запутанного обмена информацией в колонии.
- Энергетическая органелла — силлакосома (Syllacosoma), гомолог митохондрии. Цикл гликозил-силикатного фосфорилирования использует ионы кремния как конечный акцептор электронов.
- Фотонный синовий (Photon Synovium) – уникальная органелла-детектор. При фиксации паттерна длительного визуального контакта гель скопофобинов переходит в жидкокристаллическую фазу, генерируя потенциал действия, передаваемый по эндоплазматическому ретикулуму специфическому (ЕР-spec.) на витреолемму.
- Локомоция – силикаглидия (Silica-gliding): Движение со скоростью до 5 мкм/сек по слою гидратированного силикатного геля, создаваемому ферментом витреазой.
ФИЗИОЛОГИЯ И ПОВЕДЕНИЕ
- Питание: Осмотрофное (поглощение летучих органических соединений, ионов металлов).
- Таксисы:
• Положительный фототаксис (к контрастному свету);
• Идеотаксис (Idiotaxis) – уникальный отрицательный таксис. Клетки детектируют стабильный паттерн обратной фотонной эмиссии (отражённый от сетчатки наблюдателя поток), что служит триггером для синхронной поляризации и «бегства» колонии, макроскопически проявляющегося как движение узора.
- Репродукция: Не наблюдается на стадии трофозоита. Предполагается формирование нового витреобиозма из дочерних клеток внутри материнской витрокисты (Vitrocystis) – покоящейся стадии, неотличимой от пузырька воздуха в герметике.
ПРАКТИЧЕСКИЕ АСПЕКТЫ И ИСТОРИЯ ИССЛЕДОВАНИЙ
- Эксперимент с репеллентом «Силоксан-7» (2001 г.): Привёл к ферментативной адаптации объекта (витреаза-θ), использовавшего репеллент как субстрат. Программа свёрнута.
- Эксперимент по взаимодействию с Bursaria truncatella (2005 г.): Зафиксирован феномен «оптического отторжения». Инфузории демонстрировали отрицательный фототаксис от зоны свечения гиперполяризованной колонии БП-7. Прямого взаимодействия не выявлено.
ВЫВОДЫ ДЛЯ НАСЕЛЕНИЯ:
Данный организм представляет собой уникальный случай симбиоза аномальной биологии и материаловедения. Его активность является прямым следствием нарушения Протокола освещения фасадов (ПД-04) и Правила 12 секунд. Колония (витреобиозм) представляет собой распределённый «сверхорганизм», чья реакция – сложный фото-механохимический рефлекс, а не проявление разума.
Населению надлежит руководствоваться Памяткой ПВ-03. Попытки самостоятельного «исследования» или «борьбы» с объектом с помощью химических средств категорически запрещены и приведут к его адаптации и усугублению ситуации.
Приложение: Микрофотография колонии Scopophacus oculofugas (окраска по методу СМАЯ-7, увел. x400).
Соблюдайте протоколы. Ваша безопасность – в вашей дисциплине.
УПТО. Лаборатория биоаномалий СМАЯ.
Разумные системы, осьминоги и иллюзия Нового года
Приветствую, читатели! Это Santry’s Singularity blog — нерегулярные заметки о жизни на пороге сингулярности. Меня зовут Игорь Santry, я техноредактор. Я завел эту колонку, чтобы собрать лучшие лонгриды и видео, которые зацепили меня за последнее время.
Мы окружены разумными системами, но не замечаем их
Обожаю осьминогов — они настоящие инопланетяне. Идеальный камуфляж, способность запасать воду в мантии для выхода на сушу, полная бесхребетность (тот редкий случай, когда это плюс и эволюционное преимущество). Но главное — они мыслят совершенно иначе, децентрализованно. Примерно две трети нейронов осьминога находятся в щупальцах, поэтому их конечности могут действовать почти самостоятельно. Если интересно узнать больше об их биологии, почитайте «Душу осьминога» Сай Монтгомери, а сегодня я хочу поговорить о фантастическом романе «Гора в море» Рэя Нэйлора.
Его действие происходит в недалеком и, чего уж там, вероятном будущем на фоне разрушения экологии Земли. На архипелаге Кондао во Вьетнаме обнаруживают осьминогов, которые развили собственную культуру. Они создают и используют орудия труда, общаются на сложном языке и, кажется, изобрели религию.
Корпорация DIANIMA покупает остров, выселяет всех жителей и отправляет туда дрим-тим из морского биолога, ветерана войны и первого в мире андроида с полноценным сознанием. Но их цель — не установить контакт с осьминогами, а изучить и запатентовать их нейробиологию для создания нового поколения компьютеров. Дальше ситуация разворачивается в духе мрачной иронии.
Дальше будут небольшие спойлеры, но удовольствия от других сюжетных линий они не испортят.
С тех пор как Кондао стал закрытой зоной под охраной DIANIMA, морская жизнь там сумела восстановиться. Однако единственный способ сохранить этот оазис — окружить его дронами, которые безжалостно уничтожают любых нарушителей границы.
Однако в этом дивном новом мире есть автономные рыболовные суда, вооруженные до зубов. Их алгоритмы засекают высокую концентрацию биомассы в районе острова, и браконьерский флот отправляется в заповедник, игнорируя любые угрозы ради прибыли.
Впоследствии выясняется, что эти суда принадлежат дочерней структуре той же DIANIMA, и охранные системы расстреливают собственные рыболовецкие корабли. И вот жуткая деталь: на судах все это время находятся похищенные с материка рабочие-рабы (вовсе не фантастическая деталь), которые видят, что плывут под огонь дронов, но не могут развернуть корабль. Штурвалом управляет ИИ без инстинкта сохранения экипажа, у него есть только KPI по вылову.
Нэйлор развивает тему зависимости от технологий и неподконтрольности больших систем, но меня особенно зацепила параллель между биологической децентрализацией сознания осьминогов и структурой корпораций.
Роман наглядно показывает, что сложные системы (будь то рой дронов, нейросеть или корпоративная бюрократия) могут проявлять свойства живого организма. Мы создали экономические и технологические структуры, которые работают по своим правилам, и даже создатели не могут полностью контролировать каждое «щупальце». Совет директоров действительно подобен мозгу осьминога: вроде бы главный орган, но конечности живут своей жизнью. Это перекликается с моими наблюдениями и книгой Дэвида Ренсимена: «Передача: как мы отдали контроль над нашими жизнями корпорациям, государствам и ИИ» (советую рецензию The New Yorker (eng)).
Мы уже окружены разумными системами, но, похоже, человечество пока не готово принять иной разум, в какой бы то ни было форме. Мы, скорее всего, даже не сразу распознаем его. Думаю, это один из новых вызовов, с которым нас сталкивает развитие технологий в XXI веке.
В недавнем интервью Александр Крайнов, директор по развитию технологий искусственного интеллекта в Яндексе, высказал интересную мысль: опиши человеку из прошлого десятилетия LLM — он без сомнений назовет эту нейросеть искусственным интеллектом. Но когда большие языковые модели действительно появились, планка признания тут же сдвинулась. Так что споры о разумности сильного ИИ будут продолжаться еще долго после его появления. Потребуется время, чтобы мы его признали, и это признание станет новым этапом взросления человечества как вида. А осмысление природы ИИ, как ни парадоксально, приведет и к признанию прав животных как мыслящих существ, просто мыслящих иначе.
Аудиовизуальное
Маттиас Кранц семь месяцев учил осьминога играть на фортепиано. Сначала попробовал светящиеся клавиши, но осьминог их возненавидел. Потом спрятал внутри инструмента искусственных крабов, но и это не помогло. Тогда Кранц собрал специальное устройство под анатомию осьминога — «лифт для крабов», который после каждой правильной ноты постепенно опускает награду все ниже.
Короткое
Музыка солнца — Александр Богачев и Наталья Киселева из Дата-арт показывают данные о солнечных вспышках за последние три года в форме музыки. Такие мультимодальные способы представления информации всегда красивы, и, порой, позволяют и замечать неочевидные закономерности.
Библиотека времени (eng) — на одной странице собраны все способы отслеживания времени: наносекунды, секунды, месяцы, годы, революционное время (десятичное время, которое ввели во Франции после революции 1789 года), шестнадцатеричное, Beats by Swatch, марсианское время и так далее и тому подобное. Очень интересно и даже немного гипнотично.
Алексей Себрант делится лучшими фотографиями Юпитера.
Популяризатор науки Александр Панчин разработал и выпустил в продажу забавную настольную игру про мракобесов. Не знаю, как вы, а я просто не мог пройти мимо.
Mass Effect и второсортная живопись рассказывает, что существует независимый журнал о видеоигровой фотографии.
Dial-A-Poem (eng) — поэтический проект, который работает с 1969 года до сих пор. Тогда поэт Джон Джорно начал записывать чтение стихов и транслировать их по телефону: снял телефонную трубку, набрал номер — услышал стихотворение. В 21 веке вы можете приобщиться к искусству и через сайт, правда вам все равно придется кликнуть по трубке.
Автор Цифрового геноцида раскопал где-то фотографии наборной кассы, которую использовали китайские типографы, вынужденные работать с тысячами разных иероглифов. А еще он нашел видео с первыми промышленными роботами СССР (как выглядят российские боты и коботы, смотрите в моем мини-репортаже).
Длинное
Рассказываю вам о попытках межвидовой коммуникации и поисках иного разума, но, пожалуй, сперва нам стоит разобраться, что означает лайк (eng). Люди уверены, что когда ставят лайк, они что-то сообщают автору поста, но автор может понимать этот сигнал совсем иначе. По ссылке исследование о значении социальных сигналов в интернете и важности контекста в коммуникациях. Помножьте описанные проблемы на бесконечность и примерно поймете, почему так сложно наладить контакт с теми же осьминогами.
Подкаст «Время и деньги» рассказывает о китобойном промысле в СССР. Казалось бы, дела давно минувших дней, пару лет назад я бы точно пропустил эту тему мимо ушей. Даже не ожидал, какие сильные чувства она вызовет сегодня. Возможно, потому что прошлой весной сам отправился «на охоту» за китами — правда, с камерой, а не с гарпуном.
Краткая история GFP (eng) — рассказ о том, как светящиеся медузы изменили современную биологию, и почему без зеленого флуоресцентного белка мы не смогли бы увидеть, что происходит внутри живых клеток.
В продолжение морской темы: Подводные дома советских энтузиастов — спецпроект про акванавтику в СССР. Большинство этих проектов остались малоизвестными — ТАСС собрал их в одну историю и показал с неожиданной стороны. Редкий случай, когда это агентство сделало что-то нестыдное.
Бензин, масло и спирт: на чем работает глубоководная инженерия — история борьбы с колоссальным давлением при глубоководных погружениях, которая начинается и заканчивается наручными часами.
Как выжили швейцарские часы (eng) — пост о неравной борьбе механики и кварцевых часов, который хорошо дополняет предыдущую тему.
Где играют дети? (eng) — важное в контексте блокировки Roblox эссе Старка Элстера, в котором он объясняет, что онлайн-игры дают детям то, чего их лишил современный мир — возможность играть и общаться без присмотра взрослых. Обычно винят технокомпании: мол, делают платформы слишком затягивающими, и дети не могут устоять, но есть другое объяснение. Цифровое пространство — последнее место, где дети могут расти без нас. Большую часть истории детство не было делом взрослых.
Дети проводили время со сверстниками вдали от взрослых — это основа развития, так до сих пор растут дети в традиционных обществах, но взрослые заняли все физические пространства, где раньше играли дети. Проложили дорожки по лесам и ручьям, открыли тайные места. Поэтому дети ищут свой мир там, где его еще можно найти — в интернете. Они находят себе лес, чтобы бродить. Да, там есть опасности, но где их нет?
Как вакцинировать мир (eng) — обнадеживающая статья о том, как бедствующая конная ферма в Западной Индии превратилась в крупнейшего в мире производителя вакцин. Мой любимый жанр: подробный анализ того, на чем держится наш современный мир.
История кибернетики в Китае (eng) от визита Норберта Винера до системного мышления Цянь Сюэсэня и «электронной революции» Мао. Спасибо Слова и деньги за наводку.
Итоги 2025 года от pornhub (eng) — один из самых честных срезов человеческой природы, культуры и общества. Только не пеняйте на меня, если вдруг почувствуете, как шатаются скрепы.
Трагическая история о том, как космические самолеты NASA X-34 сгнили на чьем-то заднем дворе (eng) — удивительно похоже на судьбу советского «Бурана». Хорошее напоминание о том, что люди везде одинаковые.
Нил Стивенсон (да, тот самый) рассказывает медицинский детектив (eng) в стиле Доктора Хауса про беднягу, в глазах которого врачи обнаружили медные волокна.
Как ученые выращивают компьютеры из клеток человеческого мозга — и почему они хотят продолжать это делать (eng). Биокомпьютеры уже играют в Pong и распознают простую речь. Пока технология сырая (если не сказать, мокрая), но развивается быстро, и это заставляет задуматься о границах допустимого.
Китайская команда микрохирургов завершила первую в мире операцию по полной реконструкции уха (eng), которое перед этим на пять месяцев пришили к стопе пациентки, чтобы не испортилось.
Артефакт
Студентка факультета моды и ученые Корнельского университета создали материал, который поглощает свет лучше любых других тканей, и пошили из него платье. Его центральная вставка отражает всего 0,13% видимого света. Для сравнения: порог для ультрачерных материалов составляет 0,5%. При этом она сохраняет насыщенный черный цвет при взгляде под углом до 60 градусов. Секрет в структуре, которую ученые скопировали у великолепной райской птицы (Ptiloris magnificus).
Под микроскопом видно, что перья птицы состоят из плотно расположенных бороздок. Они направляют свет внутрь структуры, где он почти полностью поглощается. Ученые взяли белую шерсть, покрасили ее в черный цвет, а затем плазменным травлением создали на поверхности крошечные шипы. Именно эти шипы и улавливают падающий свет. К сожалению, камера не передает реальный эффект — в жизни материал выглядит как черная дыра.
Получилось неплохое дополнение к гардеробу из паучьего шелка и платью из миллионов живых океанских водорослей.
Полезное
Математические основы того, почему вы не можете сосредоточиться на работе (eng) — Кан Дурук решил выяснить, как прерывания влияют на продуктивность — и описал рабочий день математическими формулами. Выяснилось: всего три параметра определяют, станет ли день продуктивным или вы потратите его зря. Автор промоделировал сотни рабочих дней и построил графики зависимостей. На них хорошо видно, в какой точке вы находитесь сейчас и что случится, если поменять хотя бы один параметр. Главный вывод прост: выключите уведомления и дайте себе хотя бы 90 минут сосредоточенной работы. Математика это подтверждает.
Неподражаемый Сергей Абдулманов рассказывает про любимый способ неблокирующего контроля — «сухую серию».
Недавние открытия, касающиеся достижения наивысшего уровня человеческой работоспособности (eng) — ученые проанализировали карьерные пути 34 тысяч выдающихся людей: нобелевских лауреатов, олимпийских чемпионов, великих композиторов и сильнейших шахматистов. Главный вывод: ранняя специализация — не лучшая стратегия для достижения величия.
Те, кто с детства занимается только одним делом, первые годы показывают быстрый рост, но потом упираются в потолок. А самые успешные люди в начале пробуют разное, изучают смежные области и растут медленнее. Зато к пику карьеры они значительно обгоняют узких специалистов. Получается, величие рождается не из раннего таланта, а из разнообразного опыта. Важны терпение и готовность учиться в разных областях.
Consensus — поисковая система на базе ИИ, которая анализирует миллионы научных статей и дает ответы на основе актуальных исследований. Вместо одного источника вы получаете спектр мнений ученых по вашему вопросу.
Промпт для поиска промокодов при помощи GPT-агента — Денис, ты сэкономил мне несколько десятков тысяч на ремонте.
Что то кончается, что то начинается…
Новый год — довольно странная концепция, если вдуматься. Год как отрезок времени вполне реален и привязан к орбитальной механике, но выбор 1 января как точки отсчета, в общем то, произволен. То же самое, кстати, с нумерацией: почему сейчас мы переходим из 2025 в 2026?
В свое время монах Дионисий Малый пытался вычислить год рождения Христа, опираясь на списки римских консулов. Мы до сих пор точно не знаем, как именно он считал, но получилось так, что 1 год н.э. соответствует 754 году от основания Рима (AUC), а само Рождество у него оказывалось в районе 25 декабря 753 AUC.
Проблема в том, что расчет, судя по всему, был неточным. В евангельском повествовании рождение Иисуса относят ко времени Ирода Великого. Следовательно, дата смерти Ирода является верхней границей возможной даты Рождества, а смерть Ирода историки обычно датируют 4 годом до н.э. Парадокс, но исторический Иисус, похоже, родился «до Рождества Христова» примерно между 6 и 4 годами до н. э причем, судя по описаниям тех событий, осенью или весной.
Еще в римской системе счисления, которой пользовался Дионисий, не существовало символа или понятия для нуля как числа, поэтому в нашем календаре нет «нулевого года»: сразу за 31 декабря 1 года до н.э. наступило 1 января 1 года н.э.
На все это накладывается проблема интервалов, ведь, если говорить о «физическом» времени, то наши календарные отрезки не равны, так что интервалы между празднованиями менялись. С 1 года н.э. по октябрь 1582 года использовался юлианский календарь (средняя длина года = 365,25 суток). С 1582 года — григорианский (365,2425 суток). Это разные единицы измерения,скрытые под одним словом год.
При переходе на григорианский календарь (1582 г.) из истории просто вычеркнули 10 дней (с 4 октября сразу стало 15-е), а позже в России все 13 дней.
Каждые 4 года (с некоторыми исключениями) добавляются лишние сутки. В году 365 дней, а в високосном — 366. Значит, что интервал между Новым годом, интервал между началом 2024 и 2025 года длиннее, чем между 2023 и 2024.
Еще периодически добавляют «високосную секунду», чтобы синхронизировать атомное и астрономическое время. С 1972 года добавлено 27 таких секунд.
В общем, на система летоисчисления — большая условность, придуманная 1500 лет назад монахом, который не знал ноля и ошибся в датах. Ученые веками подгоняли ее под вращение Земли, и все эти костыли до сих пор доставляют боль историкам, астрономам и программистам.
Мы цепляемся за Новый год, потому что он нужен для социальной синхронизации. Это договоренность одновременно обнулить счетчик, чтобы координировать экономику, документооборот и планирование. Предлагаю вам ненадолго отбросить эту условность, не строить планы или читать очередные итоги года, а сделать что-то прямо здесь и сейчас. Пускай это будет самая малость, но такая, чтобы людям поблизости стало лучше. Тогда следующий произвольный промежуток времени для всех станет немного светлее.
Бонусные посты из моего ТГ-канала
Подкожный имплантат восстанавливает ощущения. Через оптоволокно и редактирование генов
Для стимуляции конкретных отделов мозга обычно используются нейроимпланты. Для их установки необходимо просверлить часть черепа и установить электроды напрямую в мозг. Но, вместо того чтобы сверлить череп и устанавливать электроды в мозг, можно использовать новое гибкое устройство. Имплант плотно прилегает к поверхности черепа, повторяет его форму и стимулирует участки мозга светом, что проходит сквозь кость. Нюанс – нужно генетически отредактировать нейроны.
Оптогенетика и регенерация
При потере конечностей, протезы могут восстановить функциональные способности. Те же протезы рук, которые сами контролируют силу захвата. Такие протезы безусловно полезны, но они не могут передавать сенсорную информацию о текстуре, влажности и плотности материалов, как это делает наша кожа.
Первое в своем роде оптогенетическое устройство из Северо-Западного университета рядом с Чикаго предлагает альтернативу. Нейроимплант, размером с ключ от дома и тоньше монеты, устраняет необходимость в трепанации черепа. Установка минимально инвазивна, так как устройство вживляется под кожу головы. Хотя, в случае утраченных конечностей, можно восстановить нейронную связь.
Нейробиологи прикладывают мягкий, гибкий «нейро-ключ» к поверхности черепа, откуда сам имплант направляет активирующий нейроны световой луч, непосредственно через череп в кору головного мозга. Буквально хакнув эволюционно развитые сенсорные каналы.
Имплант мозга, оптика и редактирование генома
В готовящейся к публикации научной статье в журнале Nature Neuroscience ученые описывают, как в экспериментах на моделях мозга мышей нейро-ключ точно активировал группы нейронов. Но сами нейроны были модифицированы геном светочувствительных водорослей. Мыши, которые не могли видеть, слышать или чувствовать, быстро научились интерпретировать световые сигналы для выполнения различных задач.
Наш мозг постоянно преобразует электрическую активность в ощущения. А эта технология дает возможность напрямую вмешаться в этот процесс. Имплантируемая платформа позволяет создать совершенно новые тип сигналов, достаточно сильный и конкретный для того, чтобы мозг научился их использовать. Технология приближает нас к восстановлению утраченных чувств после травм или болезней, а также открывает окно в понимание основных принципов, позволяющих нам воспринимать мир.
Руководитель эксперимента Евгения Козоровицкая, профессор нейробиологии.
Для работы оптогенетических имплантатов необходима генетическая модификация нейронов, поэтому они пока не одобрены для использования у человека. В то же время, если говорить про конечности, то можно вживить в остатки нервной ткани специальные магниты. А сами протезы устанавливать «поверх тела», минимально инвазивно для человека.
От улучшения имплантов к регенеративной медицине
Нейро-ключ рассматривается как потенциальный инструмент для людей, потерявших способность видеть, слышать или чувствовать. А именно, работая в паре с устройствами, способными передавать информацию, стимулирующую те же нейроны, которые получают информацию от наших глаз, ушей и кожи.
Это уже потенциал для реабилитации, особенно после неврологических последствий инсульта, а также возможности для более точечного управления роботизированными руками, кистями, ногами и ступнями.
Также технологию можно использовать для облегчения хронической боли. Нейро-ключ может управлять ощущением боли без побочных эффектов и риска привыкания, связанного с опиоидами и системно потребляемыми препаратами, наравне с новыми поколениями обезболивающих.
Светодиоды и стимуляция мозга
В первой статье команда использовала один микро-светодиод. Но уже отмечают, что новый подход с массивом из 64 микро-светодиодов создает практически бесконечное количество паттернов, различающихся по «частоте, интенсивности и временной последовательности». Управление каждым светодиодом в реальном времени позволяет передавать сложные световые паттерны в мозг, чтобы имитировать сенсорный опыт распределенной нейронной активности, а не узкой, локализованной активации.
Разработка этого устройства потребовала от нас переосмысления подхода к доставке направленной стимуляции в мозг в формате, который был бы одновременно минимально инвазивным и полностью имплантируемым. Благодаря интеграции мягкой, гибкой матрицы [до 64] микро-светодиодов, каждый из которых диаметром в человеческий волос, с модулем управления и беспроводным питанием, мы создали систему, которую можно программировать в режиме реального времени. При этом система остается под кожей, без какого-либо заметного влияния на естественное поведение субъектов.
Комментарий ученых.
По словам ученых, конструктивные особенности нейроключа это сам по себе «значительный шаг в создании устройств, которые могут взаимодействовать с мозгом без необходимости использования громоздких проводов или внешнего оборудования», и представляют ценность не только для нейробиологических исследований, но и потенциально могут улучшить здоровье человека.
И традиционно, для тех, кто ищет больше материалов о трансгуманизме, киберпанке, здоровом улучшении и расширении возможностей организма – приглашаю в сообщество Neural Hack. Подписывайтесь, чтобы первыми получать свежие материалы!
Наука вне закона: Как генетик Дмитрий Беляев в Сибири тайно взломал код доброты и за 50 лет превратил диких лис в собак
В середине XX века, когда генетика в СССР была объявлена лженаукой, а ее сторонники рисковали свободой, советский ученый Дмитрий Беляев начал в Новосибирске один из самых дерзких экспериментов в истории. Под прикрытием обычной зверофермы по разведению серебристых лис он пошел на огромный риск, чтобы тайно ответить на вопрос: можно ли приручить чистую ярость и повторить тысячелетний путь эволюции всего за 50 лет?
Все началось в 1959 году в новосибирском Академгородке, на базе Института цитологии и генетики. Официально Беляев занимался разведением серебристо-черных лис для нужд меховой промышленности — это было идеальное прикрытие. На самом же деле его интересовала одна из величайших загадок эволюции: как дикий, кровожадный волк превратился в верного друга человека — собаку? Беляев предположил, что наши предки отбирали волков не по силе или уму, а по одному признаку — терпимости к человеку.
Эксперимент был до гениальности прост. Из сотен лис на звероферме Беляев и его команда отбирали для размножения лишь несколько особей — тех, кто проявлял наименьшую агрессию. Они просто протягивали руку в перчатке к клетке. Тех, кто впадал в ярость, отбраковывали. Тех, кто проявлял хотя бы долю любопытства или терпимости, допускали к следующему поколению. Год за годом, поколение за поколением, они искали не лучший мех. Они искали ген доброты.
Под постоянной угрозой доносов и репрессий со стороны последователей «лысенковщины», команда Беляева продолжала свою кропотливую работу. И уже через несколько поколений стали происходить чудеса. Лисы перестали бояться людей. Они начали вилять хвостами, скулить и подставлять животы, чтобы их почесали. Но затем случилось то, чего не ожидал никто. Вместе с характером начала меняться их внешность.
Это было невероятное открытие. У потомков самых дружелюбных лис уши стали обвисать, как у спаниелей. Хвосты закрутились колечком, как у лаек. Жесткий серебристый мех покрылся белыми «звездочками» и пятнами, как у бордер-колли. Даже их черепа стали меняться, больше напоминая собачьи, чем лисьи. Они начали издавать звуки, похожие на тявканье. Отбор по одному-единственному гену поведения запустил целую цепную реакцию, изменившую животных до неузнаваемости.
Дмитрий Беляев совершил прорыв. Он наглядно доказал, что за процессом одомашнивания стоит отбор по нейрохимическим системам мозга, отвечающим за стресс и агрессию. Снижая уровень адреналина, он невольно изменил и десятки других генов, связанных с пигментацией, хрящевой тканью и строением скелета. Он сжал 15 000 лет эволюции в полвека.
Сегодня новосибирские одомашненные лисы известны всему миру. Они — живой памятник не только гению одного ученого, но и его мужеству. Дмитрий Беляев в сибирской тиши доказал, что у доброты есть свой генетический код. И если его найти, можно приручить даже самую дикую ярость.
Российские ученые изучили, как черная плесень нейтрализует трибутилфосфат
Обычно, увидев черную плесень в помещении, мы стремимся избавиться от нее как можно скорее. Микроскопический гриб Aspergillus niger обладает уникальной живучестью и умением приспосабливаться к любым неблагоприятным условиям среды, но для человека воспринимается как признак бытовой неприятности. Он портит еду, размножается в сырых углах, вызывает аллергию и ассоциируется с антисанитарией. Однако именно эти качества — устойчивость к токсичным веществам и способность расти в экстремальных условиях — оказались ключевыми для неожиданной сферы его применения. Ученые задействовали этот гриб для утилизации одного из самых проблемных промышленных загрязнителей — трибутилфосфата.
Исследование опубликовано на английском языке в издании Biology Bulletin Reviews, на русском — в журнале «Микология и фитопатология».
Трибутилфосфат (ТБФ) — органическое соединение, представляющее собой эфир ортофосфорной кислоты и н-бутанола. Это вязкая, бесцветная, плохо растворимая в воде жидкость, обладающая высокой растворяющей способностью по отношению к ряду металлов и их соединений. Благодаря этим свойствам ТБФ нашел широкое применение как экстрагент при переработке отработанного ядерного топлива и выделении урана и плутония, в качестве компонента флотационных реагентов для разделения трудноотделимых металлов, таких как цирконий и гафний, а также при производстве пластификаторов, гербицидов, пеногасителей и гидравлических жидкостей.
Мировое производство ТБФ составляет десятки тысяч тонн в год, и следы этого соединения регулярно обнаруживаются не только в промышленных стоках, но и в почве, воздухе, воде, продуктах питания и даже в тканях человека — в том числе в плаценте.
ТБФ относится к классу органофосфатных соединений, известных своей высокой токсичностью. Он является специфическим ингибитором ферментов, включая ацетилхолинэстеразу, бутирилхолинэстеразу, липазы и протеазы. В результате нарушается передача нервных импульсов и работа мышц, что может привести к резкому снижению двигательной активности, параличу дыхания и даже гибели водных и наземных организмов.
Кроме того, ТБФ — липофильное соединение, то есть легко проникает через биологические мембраны и накапливается в тканях живых организмов, особенно в жировой ткани и печени. Уже при низких концентрациях он вызывает гибель водных микроорганизмов, рачков и рыб. В экспериментах, описанных в статье, среда с ТБФ даже при 50-кратном разбавлении убивала 25% инфузорий Paramecium caudatum за час, а при 8-кратном — 60% рачков Artemia salina.
Поэтому разработка эффективных, экологически безопасных методов его утилизации — одна из актуальных задач современной биотехнологии.
Рост Aspergillus niger F-4815D через пять суток после посева: а — на среде с фосфатами без трибутилфосфата, б — на среде с 0,01% трибутилфосфата и фосфатами, в — на среде с 0,01% трибутилфосфата без фосфатов / © «Микология и фитопатология»
Предыдущие исследования показали, что два штамма Aspergillus niger (F-4815D и его «дочерний» вариант F-4816D) способны использовать в качестве источника фосфора, необходимого для жизни, даже такое ядовитое вещество как белый фосфор. Это навело группу ученых из Казанского национального исследовательского технологического университета, Казанского научного центра РАН, Института проблем промышленной экологии Севера Кольского научного центра РАН и Российского университета дружбы народов на мысль проверить способность этих плесневых грибов использовать для роста и органический фосфорсодержащий токсин — ТБФ.
Колонии Aspergillus niger F-4815D через 12 суток после посева: а — среда Чапека, б — среда Чапека + трибутилфосфат, в — среда Чапека без фосфатов, г — среда Чапека без фосфатов + трибутилфосфат / © «Микология и фитопатология»
В экспериментах грибы выращивали на среде Чапека с добавлением 0,01% ТБФ — как при наличии, так и при отсутствии неорганических фосфатов. Оба штамма выжили в присутствии ТБФ, а дочерний штамм F-4816D, полученный путем искусственного отбора, показал наиболее высокую устойчивость. В отсутствие других источников фосфора его рост даже усиливался в среде с ТБФ. Это позволяет предположить, что гриб расщепляет ТБФ на менее токсичные продукты — дибутилфосфат, монобутилфосфат, а затем — на неорганический фосфат и бутанол, которые использует в своем метаболизме.
Конидиеносцы Aspergillus niger F-4815D: а — среда Чапека, б — среда Чапека + трибутилфосфат, в — среда Чапека без фосфатов, г — среда Чапека без фосфатов + трибутилфосфат / © «Микология и фитопатология»
То, что мы обычно считаем недостатком — упрямую способность плесени выживать в токсичных условиях, — стало ее главным достоинством. Благодаря этой устойчивости Aspergillus niger может колонизировать загрязненные зоны и выполнять функцию биологического детоксиканта.
Колонии Aspergillus niger F-4816D через 12 суток после посева: а — среда Чапека, б — среда Чапека + трибутилфосфат, в — среда Чапека без фосфатов, г — среда Чапека без фосфатов + трибутилфосфат / © «Микология и фитопатология»
Перспективы применения штамма F-4816D включают:
создание биофильтриров и биореакторов с микроскопическими грибами для очистки промышленных сточных вод от ТБФ и связанных с ним металлов;
рекультивацию почв на участках добычи и переработки руд.
Конидиеносцы Aspergillus niger F-4816D: а — среда Чапека, б — среда Чапека + трибутилфосфат, в — среда Чапека без фосфатов, г — среда Чапека без фосфатов + трибутилфосфат / © «Микология и фитопатология»
Это особенно важно для регионов с развитой горнодобывающей или ядерной промышленностью, включая Мурманскую область, где присутствуют предприятия, работающие с редкими и радиоактивными металлами.
Альголизация - реклама против науки. Продолжение (12)...
Рекламный постулат №12 "16 февраля представителями ООО ПО «Макрос» произведено внесение хлореллы в городской пруд. Следующее внесение запланировано в период с апреля по май. Хочется надеяться на содействие камешковцев в поддержании чистоты вокруг пруда на улице Володарского и бережное отношение к водоемам города." https://time33.ru/news/2022/02/24/8853-v-kameshkovski..
В каждом исследовании о культивировании зеленой микроводоросли Хлорелла Вульгарис (Chlorella Vulgaris), подчеркивается зависимость активности хлореллы от трех факторов: освещенность, pH, температура.
В научном исследовании "Очистка канализационных стоков с помощью микроводоросли Хлорелла Вульгарис в целях параллельной очистки стока и выращивания биомассы. Sewage Water Treatment Using Chlorella Vulgaris Microalgae for Simultaneous Nutrient Separation and Biomass Production", научный журнал Separations, 2023, 10(4), 229; https://doi.org/10.3390/separations10040229, 7 марта 2023, Источник https://www.mdpi.com/2297-8739/10/4/229, читаю: "Однако, способность микроводоросли понижать ХПК в сточной воде ограничена количеством света, аэрации, и начальной концетрацией загрязнителей в сточной воде. Хотя в начальных исследованиях использовали высококонцетрированные стоки, с целью подстегнуть снижение ХПК, дальнейшее повышение концентрации стока не привело к повышению эффективности очистки в настоящем исследовании. Это можно объяснить высокой концентрацией взвешенных веществ и мутностью, затрудняющими проникновение света и рост биомассы.",- и еще "К сожалению, большие водорослевые очистные сооружения не распространены. Это может быть результатом технических трудностей связанных с культивированием микроводорослей и отделением микроводорослей от очищенной воды. Действительно, поскольку микроводоросли являются фотосинтетическими организмами, такие параметры как свет, температура, и pH, очень сильно влияют на то, как микроводоросли смогут очищать стоки. Наибольшую трудность представляет поддержание оптимальной температуры, Ph, освещенности. Эти моменты должны очень тщательно контролироваться в крупномасштабных системах." Конец цитаты.
Мой вопрос заключается в том, а какую эффективность для очистки водоема может иметь Хлорелла Вульгарис при внесении зимою под лед, то есть при полном отсутствии освещения, и температуре не выше +3 градусов Цельсия ? Испачканные зеленью лунки во льду, с гордостью демонстрируемые в рекламе альголизации, не вызывают когнитивного диссонанса ? Оптимальной для культивирования хлореллы температурой, т.е. при которой хлорелла дает максимум биомассы, разные источники называют диапазон от +20-25 до +30-35 градусов Цельсия. Известно о существовании холодотолерантных хлорелл, способных приспосабливаться к температуре +5 градусов Цельсия, хотя при такой температуре не стоит ожидать большой эффективности.
В исследовании "Резкое охлаждение стимулирует микроводоросли к производству полезных компонентов. Cold stress stimulates algae to produce value-added compounds" https://doi.org/10.1016/j.biteb.2022.101145 28 Февраля 2022, Источник: https://www.sciencedirect.com/science/article/pii/S25.. , говорится: "Две устойчивые к холоду микроводоросли Chlorella vulgaris и Scenedesmus sp. , культивировали при +22 градусах Цельсия и +5 градусах Цельсия. При наименьшей температуре , микроводоросли претерпели существенные биохимические и морфологические изменения.", также " Содержание глюкозы и фруктозы в Chorella Vulgaris (выращенной при температуре +22 градуса Цельсия) было очень низким или пренебрежимым, ограниченный, хотя, статистический значимый рост глюкозы обнаружился при выращивании Chlorella Vulgaris при температуре +5 градусов Цельсия."
Способна ли Хлорелла Вульгарис расти в темноте ?
Зеленые водоросли, включая Хлореллу Вульгарис, могут расти в темноте, если их подкармливать глюкозой, но темпы их роста при этом сильно отстают от темпов роста при нормальном фотосинтезе, говорится в научном исследовании "Особый эффект освещения на рост Хлорелла Вульгарис A Special Effect of Light on the Growth of Chlorella vulgaris" Авторы: Allen Killam, Jack Myers American, научный журнал Journal of Botany, Выпуск 43, Номер 8 (Октябрь, 1956), стр. 569-572 (4 страницы) Источник: https://doi.org/10.2307/2438870 https://www.jstor.org/stable/2438870
А вот что говорят по этому поводу авторы альголизации в статье "Принцип действия планктонной хлореллы в водоеме" по ссылке https://algotec.ru/principle : "В зимний период, когда хлорелла не может активно размножаться (из-за низкой температуры воды и/или отсутствия достаточного количества света подо льдом), она практически полностью съедается зоопланктоном."
Практически полностью съедается зоопланконом ? Тогда какой смысл вкладывает альголизация в следующее действие ?
"16 февраля представителями ООО ПО «Макрос» произведено внесение хлореллы в городской пруд. Следующее внесение запланировано в период с апреля по май. Хочется надеяться на содействие камешковцев в поддержании чистоты вокруг пруда на улице Володарского и бережное отношение к водоемам города." https://time33.ru/news/2022/02/24/8853-v-kameshkovski..
Внесение концентрата водоросли Хлорелла Вульгарис под лед
предусмотренное технологией альголизации
Задаю вопрос непосредственно российскому производителю водоросли Хлорелла Вульгарис для водоемов:
- Так все таки за счет каких механизмов водоросль Хлорелла Вульгарис подавляет рост сине-зеленых водорослей ?
- @AlgotecAqua За счёт механизма межвидовой конкуренции. Будучи более продуктивной в скорости деления клетки, хлорелла быстрее забирает питательные элементы (азот и фосфор и др.) для своего развития.
- Зимой подо льдом ? При полном отсутствии освещения и температуре +3 градуса ?
- @AlgotecAqua Чтобы дать хлорелле преимущество во времени, мы рекомендуем зимнее внесение (под лёд). Тогда весной она успеет занять весь ареал ещё до того, как начнут развиваться болезнетворные организмы, такие как цианобактерии.
- На вашем сайте https://algotec.ru/principle вы пишете, что зимой хлореллу полностью съедает зоопланктон. Определитесь. Преимущество во времени ? В чем заключается это преимущество, если, как вы пишите на вашем сайте, хлорелла подо льдом не может расти из за отсутствия света из за низкой температуры и полностью съедается зоопланктоном ? Я цитирую ваш сайт https://algotec.ru/principle, статья "Принцип действия планктонной хлореллы в водоеме". А, если, как вы говорите "Будучи более продуктивной в скорости деления клетки, хлорелла быстрее забирает питательные элементы (азот и фосфор и др.) для своего развития." , то для чего преимущество во времени, если хлорелла уже, с ваших слов, имеет огромное преимущество в продуктивности ? "
- @AlgotecAqua Короткие гудки.... https://www.youtube.com/watch?v=2afgGN4y1js&lc=Ug..
Научное исследование "Физиологические и ростовые реакции Chlorella vulgaris и Scenedesmus subspicatus на ряд условий окружающей среды" PHYSIOLOGICAL AND GROWTH RESPONSES OF Chlorella vulgaris AND Scenedesmus subspicatus TO'A RANGE OF ENVIRONMENTAL FACTORS UNIVERSITY OF SOUTHAMPTON FACULTY OF ENGINEERING, SCIENCE & MATHEMATICS School of Civil Engineering and the Environment by Yelena Bartosh https://eprints.soton.ac.uk/465831/1/1000046.pdf : "Эксперименты по выживанию показали, что часть клеток C. vulgaris способны выживать в течение длительных периодов (до 22 недель) в спящем состоянии в полной темноте и при низких температурах (+4 и -20 градусов Цельсия)." Конец цитаты.
Зимой подо льдом Хлорелла выживает в спящем состоянии. До весны доживет только часть клеток, если их полностью не выест зоопланктон, как обещано в рекламе. Для того, чтобы достичь "полного избавления водоема от сине-зеленых водорослей", процедуру "альголизации" необходимо повторять три-четыре-пять лет подряд. А нет ли чего-нибудь поэффективнее, такого, чтобы годами лунки во льду не долбить, и четыре весны подряд ноги на весеннем льду не морозить ? Учитывая, что никаких научных оснований для того, чтобы рассчитывать на обещанное в рекламе альголизации счастье, не существует.
В следующей главе - водоем это не комфортный биореактор в лаборатории.
Альголизация - реклама против науки. Продолжение (8)...
Рекламный постулат №8 "За несколько дней хлорелла становится доминирующей микроводорослью в поверхностном слое воды, насыщая его кислородом и удаляя из него излишки углекислого газа, различные органические и неорганические загрязнения.",- ,- пишет российская компания производитель хлореллы в статье "Принцип действия планктонной хлореллы в водоеме" на сайте https://algotec.ru/principle.
Статья "К вопросу об альголизации водоемов" © 2013 г. Е.А. Бутакова, Т.Е. Павлюк, О.С. Ушакова, А.Н. Попов, О.В. Тютков ФГУП «Российский научно-исследовательский институт комплексного использования и охраны водных ресурсов», г. Екатеринбург Ключевые слова: альголизация, хлорелла, «цветение» водоемов. УДК 574.5 https://cyberleninka.ru/article/n/k-voprosu-ob-algoli.. : "Обоснование механизма воздействия альголизации на водный биоценоз ее авторы строят на основе декларируемых ими свойств штамма Chlorella vulgaris ИФР № С-111: после внесения в водоем этот штамм за считанные дни становится доминирующей микроводорослью в указанном биотопе, поглощает все биогенные элементы и органические вещества, за счет чего вытесняет синезеленые водоросли. Проведенные в ФГУП РосНИИВХ исследования (тесты и эксперименты) показали, что синезеленые водоросли по-разному реагируют на присутствие культуры штамма Chlorella vulgaris ИФР № C-111. Среди изученных 11 культур синезеленых водорослей только 4 погибли в присутствии хлореллы. Остальные смогли через некоторое время адаптироваться и даже начать развиваться, а на одну культуру (№ 535, Synechococcus sp.) хлорелла оказала стимулирующее действие. Наиболее эффективно хлорелла подавляет развитие синезеленых водорослей в большой концентрации, когда плотности сопоставимы, или плотность хлореллы превышает плотность синезеленых водорослей. Речь в данном случае идет об очень высокой численности хлореллы – от 3 до 8 млрд кл./л (млн кл./мл), которая наблюдалась от начала и до конца эксперимента. При таких условиях хлорелла успешно размножается и подавляет развитие не только синезеленых, но и зеленых водорослей.В остальных соотношениях действие более непредсказуемо и, по всей вероятности, зависит от общего состава, плотности и состояния альгоценоза." Конец цитаты.
3 млрд. клеток в литре это в 3 000 раз больше допустимой нормы концентрации фитопланктона для водоемов !
В статье "Цветение водоёмов: причины и последствия" Романов Эдуард Викторович Лелецкий Александр Владимирович https://cyberleninka.ru/article/n/tsvetenie-vodoyomov., сказано: "Одноклеточные водоросли и бактерии в некотором количестве присутствуют в каждом естественном водоеме. Нормальной считается концентрация 100-1000 клеток на один миллилитр, зависимо от их размера." Конец цитаты.
Исследование "Биоремедиация стоков молочного завода и оценка потенциала удаления питательных элементов с помощью Chlorella Vulgaris Bioremediation of dairy industry wastewater and assessment of nutrient removal potential of Chlorella vulgaris. C., S.M., Perumalsamy, M. Bioremediation of dairy industry wastewater and assessment of nutrient removal potential of Chlorella vulgaris.", журнал Biomass Conv. Bioref. (2022), https://doi.org/10.1007/s13399-022-03068-x , Июль 2002, Источник: https://link.springer.com/article/10.1007/s13399-022-03068-x: " Поскольку мутность сточной воды была высокой, сток молочного производства разбавили дистиллированной водой в различных концентрациях 100%, 75%, 50% и 25%. Chlorella vulgaris показала многобещающий результат при росте на стоке молочного производства , с максимальной концентрацией биомассы 225 грамм/литр/день. В целом, результаты биоремедиации показали максимальную эффективность очистки 81.48% (ХПК), 87.7 %(общий азот) , и 93.5 %( общий фосфор)." Конец цитаты.
Из публикации следует, что приемлемые результаты очистки стоков молочного завода Хлорелла показала при плотности клеток хлореллы 225 грамма на литр/день, для набора которой необходимо строгое соблюдение оптимальных факторов: температуры, pH, освещенности. По показателю плотности клеток, при такой концентрации клеток Хлореллы, водоём должен быть отнесен к какому классу качества воды ?
Исследование "Фитопланктон как показатель качества воды разнотипных водоёмов территории города Омска". текст научной статьи по специальности «Биологические науки»., автор О.А. Коновалова УДК 581.526.325:626 (571.13)https://cyberleninka.ru/article/n/fitoplankton-kak-po.. : "Биомасса фитопланктона за годы исследований в среднем по озеру колебалась в пределах 53,58-111,26 г/м 3 , по данному показателю водоём относится к 5 классу качества вод — «грязная», разряду «весьма грязная» или «предельно грязная». Видовой состав, структура и особенно высокие показатели биомассы фитопланктона свидетельствуют, что оз. Солёное является гипертрофным водоемомИз-за высокой минерализации воды «цветение» озера вызывается не обычными видами цианобактерий, характерными для эвтрофных вод Омского Прииртышья [4], а мезогалобом S. fusiformis." Конец цитаты.
111 граммов на один кубический метр воды и 225 граммов на один литр воды в день.
Научная статья "УЛУЧШЕНИЕ КАЧЕСТВА ВОД АРКТИЧЕСКИХ РЕГИОНОВ – ХЛОРЕЛЛА: БЛАГО ИЛИ ЗЛО?" Д.Б. Денисов, Вестник Гиперборейской академии наук. Сборник трудов ГАН. Апатиты,
ГАН. №1. 2016 г. – 43 с. Источник: http://discoverkola.com/images/books/Vestnik_GAN_1_2016.pdf : "Эффективность мероприятий по коррекции альгоценоза водных объектов Мурманской области хлореллой вызывает сомнения, так как это не является методом снижения трофической нагрузки на водоем. Сохраняющаяся нагрузка биогенными элементами обуславливает высокую биомассу водорослей, не типичную для региона, независимо от того, какими видами водорослей она представлена. Самоочищение водоема, которое предлагается ООО НПО «Альгобиотехнология», возможно только при снижении или прекращении поступления биогенных элементов в водоемы, чего сложно ожидать в ближайшие десятилетия. Коррекция альгоценоза суть борьба со следствием, в то время как следует бороться с причинами. Внесение нового, устойчивого эврибионтного вида водорослей может вызвать разбалансировку экосистем, наруше ние трофических связей и биогеохимических циклов с последующим изменением качества водных и биологических ресурсов. Последствия подобных мероприятий для региона можно определить, как сложно прогнозируемые. .... Следует также учесть, что «альголизация» не решает основную причину ухудшения качества вод – антропогенное загрязнение и эвтрофирование. Наиболее целесообразным представляется проведение дополнительных исследований влияния штаммов хлореллы на биоценозы и качество вод Евро-Арктического региона с целью выявления возможных последствий для экосистем." Источник: http://discoverkola.com/images/books/Vestnik_GAN_1_2016.pdf
В следующей главе я задам компании -производителю Хлорелла Вульгарис вопрос об отношении к решению XI Съезда гидробиологов РАН о признании альголизации ложным, наносящим значительный вред российской гидробиологии путем.
![Вид: Scopophacus oculofugas. Объект БП-7. Отчёт Лаборатории биоаномалий. Научная справка №447-БП/ВС. [РАСЕКРЕЧЕНО] СМАЯ](https://cs18.pikabu.ru/s/2026/01/02/23/ng7rcdnf.jpg)